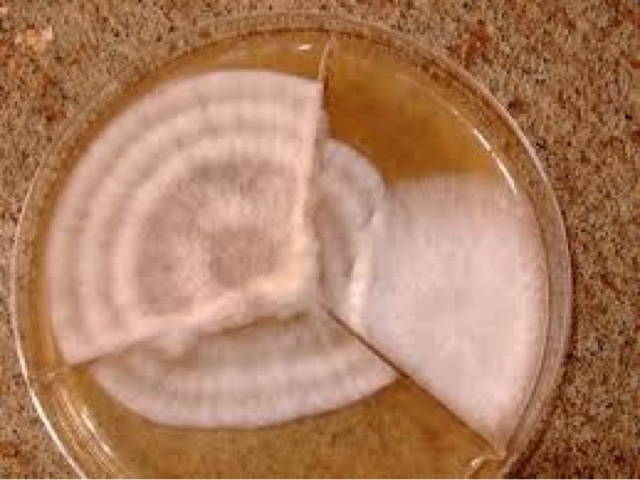

Ризоморфный мицелий: фотовыборка

Раздел: Природная галерея